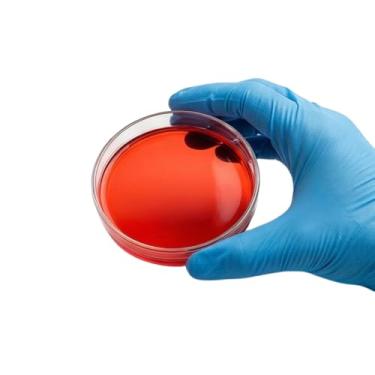
Imagem de Placa de Petri para cultura vegetal 100 x 15 mm, poliestireno estéril, empilhável, SPL Life Sciences, embalagem com 10 placas

Você buscou
Placa de petri
Preços
Mais de 45 resultados

R$ 401,99
Publicidade
Publicidade
- 1
- 2
FAQ
Explique o que é a interconexão expressa de componentes periféricos (PCI Express).
A interconexão expressa de componentes periféricos (PCI Express) é a última evolução da PCI que utiliza conceitos de programação PCI e padrões de comunicação existentes. No entanto, ela foi aprimorada para proporcionar um melhor desempenho, a fim de acompanhar as velocidades mais altas dos computadores modernos.
Publicidade
Filtros
Preços
45 produtos nesta faixa de preço
até

![Imagem de Vabiooth [Autoclavável] 500 Pacotes De Placas De Petri De Plástico Grosso Estéreis Com Tampa, 90 Mm De Diâmetro X 15 Mm De Profundidade Placa De Petri Transparente Com 3 Ventilação Para Experimento](https://i.zst.com.br/thumbs/51/29/35/-1455886619.jpg)